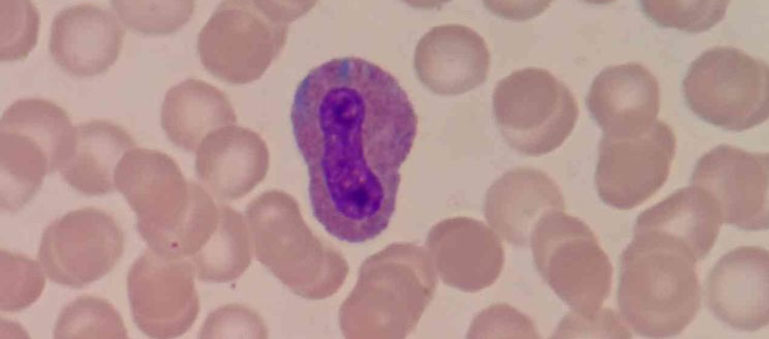

新生儿遗传和代谢病基因检测
“贝可康”新生儿遗传和代谢病基因检测产品,采用9888拉斯维加斯“All-in-One” 超高重PCR扩增子捕获的专利技术和二代高通量测序技术,对新生儿可干预的165余种遗传病进行检测。

.png)
深圳9888拉斯维加斯科技有限公司是一家专注于遗传病和生殖健康领域的高新技术企业,为新生儿及儿童提供专业的基因检测,在高通量测序技术和生信数据分析方面具有丰富经验,致力于成为出生缺陷预防领域的领军企业。
公司技术研究团队位于美国哈佛大学,并与香港科技大学建立密切科研合作。公司拥有基因检测技术,全自动化的生物信息分析系统,表型与基因型关联数据库,可提供遗传
病NGS检测和分析整套自动化和本地化的解决方案。承担了深圳市孔雀计划技术研发项目,深圳市核心技术突破项目等科研攻关项目,现已申请了多项国内、国际专利和软件著作权。
公司拥有一支高素质综合团队,由深圳市孔雀计划人才、生物医学博士、顶尖生物信息分析人才、遗传解读专家组成。首席科学家和学术带头人来自香港科技大学和哈佛大学,并汇聚了国内外优秀的医学专家,赢得了临床客户的高度认可。
遗传代谢病134种

苯丙酮尿症
BH4 缺乏型高苯丙氨酸血症 A 型
BH4 缺乏型高苯丙氨酸血症 C 型
非 BH4 缺乏型轻度高苯丙氨酸血症
BH4 缺乏型高苯丙氨酸血症 D 型
BH4 缺乏型高苯丙氨酸血症 B 型
墨蝶呤还原酶缺陷型多巴反应性肌张力障碍
酪氨酸血症 I 型
酪氨酸血症 II 型
酪氨酸血症 Ⅲ 型
枫糖尿病Ⅰa 型
枫糖尿病Ⅰb 型
枫糖尿病Ⅱ型
枫糖尿症III型
瓜氨酸血症I型
Citrin缺乏症
N-乙酰谷氨酸合成酶缺乏症
精氨酸血症
甘氨酸脑病
精氨酰琥珀酸尿症
鸟氨酸氨甲酰基转移酶缺乏症
氨甲酰磷酸合成酶I缺乏症
鸟氨酸氨基转移酶缺乏症
高鸟氨酸血症-高氨血症-同型瓜氨酸尿症
胱硫醚β-合成酶缺陷型同型半胱氨酸尿症
同型胱氨酸尿症-巨幼红细胞性贫血cblG 型
同型胱氨酸尿症-巨幼红细胞性贫血cblE 型
亚甲基四氢叶酸还原酶缺陷型同型半胱氨酸尿症
高甲硫氨酸血症(甲硫氨酸腺苷转移酶I/III缺陷)
高甲硫氨酸血症(甘氨酸N-甲基转移酶缺陷)
高甲硫氨酸血症(S-腺苷同型半胱氨酸水解酶缺陷)
高脯氨酸血症1型
高脯氨酸血症2型

cblC 型甲基丙二酸血症合并高胱氨酸尿症
cblD 型甲基丙二酸血症合并高胱氨酸尿症
cblF 型甲基丙二酸血症合并高胱氨酸尿症
cblX 型甲基丙二酸血症合并同型半胱氨酸尿症
cblJ 型甲基丙二酸血症合并高胱氨酸尿症
甲基丙二酰辅酶A变位酶缺陷型甲基丙二酸尿症
甲基丙二酸血症 cblA 型
甲基丙二酸血症 cblB 型
线粒体 DNA 耗竭综合征 5 型
线粒体 DNA 耗竭综合征 9 型
甲基丙二酰辅酶 A 差向异构酶缺乏症
联合丙二酸和甲基丙二酸尿症
转钴胺素蛋白受体缺陷型甲基丙二酸尿症
甲基丙二酸半醛脱氢酶缺乏症
丙酸血症
异戊酸血症
戊二酸血症Ⅰ型
3-甲基巴豆酰辅酶A羧化酶 1 缺乏症
3-甲基巴豆酰辅酶A羧化酶 2 缺乏症
3-甲基戊烯二酸尿症Ⅰ型
Barth 综合征
3-羟基-3-甲基戊二酰辅酶A裂解酶缺乏症
全羧化酶合成酶缺乏症
生物素酶缺乏症
β-酮硫解酶缺乏症
2-甲基丁酰辅酶A脱氢酶缺乏症
异丁酰辅酶A脱氢酶缺乏症
L-2-羟基戊二酸尿症
乙基丙二酸脑病
丙二酰辅酶 A 脱羧酶缺乏症(丙二酸血症)

原发性肉碱缺乏症
肉碱棕榈酰转移酶 I 缺乏症
肉碱棕榈酰转移酶 II 缺陷
肉碱-酰基肉碱移位酶缺乏症
短链乙酰辅酶 A 脱氢酶缺乏症
中链乙酰辅酶 A 脱氢酶缺乏症
极长链酰基辅酶 A 脱氢酶缺陷症
长链-3-羟酰基辅酶A脱氢酶缺乏症线粒体三功能蛋白缺乏症
线粒体三功能蛋白缺乏症
多种酰基辅酶A脱氢酶缺乏症(戊二酸血症II型)
3-羟酰基辅酶A脱氢酶缺乏症家族性高胰岛素血症性低血糖症4型
家族性高胰岛素血症性低血糖症4型
2,4-二烯酰辅酶A还原酶缺乏症

黏多糖贮积症I型
黏多糖贮积症 II 型
黏多糖贮积症 IIIA 型(Sanfilippo A)
黏多糖贮积症 IIIB 型(Sanfilippo B)
黏多糖贮积症 IVA 型
黏多糖贮积症 IVB 型(Morquio)
黏多糖贮积症 VII
黏多糖贮积症 VI 型
尼曼匹克病 A/B 型
尼曼匹克病 C1型
尼曼匹克病 C2 型
戈谢病
法布里病
Tay-Sachs 病
克拉伯病
鞘脂酶激活蛋白缺乏症
异染性脑白质营养不良
糖原累积病Ⅱ型
黏脂贮积症II/III型
GM1神经节苷脂贮积症

糖原贮积症Ⅰa 型
糖原贮积症 Ib/Ic 型
糖原贮积症 Ⅲ 型
糖原贮积病 VI 型
糖原贮积症 IX 型
半乳糖血症
半乳糖激酶缺乏症
半乳糖异构酶缺乏症
遗传性果糖不耐
丙酮酸羧化酶缺乏症

吡哆醇依赖型癫痫
吡哆胺5’-磷酸氧化酶缺乏症
Neu-Laxova综合征1型
磷酸甘油酸脱氢酶缺乏症
磷酸丝氨酸转氨酶缺乏症
磷酸丝氨酸磷酸酶缺乏
脑肌酸缺乏综合征 3 型
脑肌酸缺乏综合征 2 型
脑肌酸缺乏综合征 1 型
Neu-Laxova 综合征2型
GLUT1缺陷综合征
常染色体隐性 Segawa 综合征
芳香族L-氨基酸脱羧酶缺乏症
11-β-羟化酶缺乏型先天性肾上腺皮质增生症
17β-羟基类固醇脱氢酶缺乏症
X-连锁肾上腺脑白质营养不良
肝豆状核变性
Menkes 病
G6PD 缺乏症
Gilbert 综合征
钠牛磺胆酸共转运多肽缺陷病
Crigler-Najjar综合征1型/2型
家族性高胆固醇血症1型
家族性高胆固醇血症2型
家族性高胆固醇血症3型
家族性高胆固醇血症4型
谷固醇血症1型
谷固醇血症2型
遗传病31种

B型血友病又称乙型血友病、PTC缺乏症、血浆凝血活酶成分缺乏综合征,是凝血因子Ⅸ缺乏所导致的出血性疾病,属性染色体隐性遗传,其特征是活性凝血活酶生成障碍,凝血时间延长,出血症状较A型血友病轻,重症病人无明显外伤也可发生自发性出血。
基因诊断血友病是一种有效精确快速的方法,目前主要采用PCR进行基因分析。
因本病属一种遗传性疾病,故要使患者本人及家属懂得优生优育的道理。若产前羊膜穿刺确诊为血友病,应终止妊娠,以减少血友病患儿的出生率。

耳聋基因在正常人群中也携带,携带耳聋基因并不代表会耳聋,夫妇听力正常也可能会生下聋儿,有耳聋病史的夫妇也可能生下听力正常的孩子。听力正常的育龄夫妇携带至少一种基因突变的几率为6.3%。因此我们认为在有生育要求但无耳聋家族遗传史的听力正常育龄夫妇中进行常见耳聋基因筛查。
耳聋基因检测就是通过对人的DNA进行检测,发现是否存在耳聋基因突变位点。对于家族中有先天性耳聋成员或者有从而明确病因,对耳聋的再次发生具有良好的预防意义。
目前已发现近300个耳聋疾病相关基因。在我国,常见的耳聋相关基因及突变热点包括GJB2(235delC、176dell6bp、512insAACG和299-300delAT), SLC26A4 (2168A>G、1229C>T 、1174A>T、IVS2-7A>G,线粒体MT-RNR1(1555A>G、1494C>T)和中国科学家克隆的第一个本土耳聋基因GJB3 (538C>T及547G>A)。
建议有生育要求的夫妇进行常见致聋基因突变的筛查,若发现双方均带有相同的突变耳聋基因,通过对其生育进行全程的指导和干预,可以预防性的减少近1/3-2/5的先天性耳聋患者出生。
产品优势

major
专业
专为新生儿筛查
设计的基因检测包
fast
快速
报告周期5~7工作日
本地开展最快36小时出报告
exact
准确
多重质控,多中心验证
表型-基因型数据库
适用人群
1、常规生化筛查、串联质谱筛查结果异常、常规听力筛查未通过的新生儿;
2、有黄疸延迟不退、喂养困难、反复呕吐、代谢性酸中毒、高血氨等遗传代谢病临床症状的患儿;
3、所有新生儿。
样本要求

干血斑

外周血
检测流程
咨询与知情同意

样本采集

样本寄送

样本检测

发送报告

遗传咨询


样本接收及信息录入

DNA提取及建库

捕获建库

高通量测序

信息分析

自动化报告

报告审核
案例分享

一位刚出生4天的宝宝的串联质谱遗传代谢病检测结果异常:
Phe和Phe/Tyr均偏高,不同的致病基因对应的治疗方案迥异
宝宝及其父母使用9888拉斯维加斯的“贝可康”新生儿常见遗传和代谢病基因检测产品:
发现宝宝携带PAH基因的致病位点
宝宝得以及时确诊:
确诊为苯丙氨酸羟化酶缺乏症
通过及时有效的治疗:
宝宝预后良好,智力发育接近正常人
解读:高苯丙氨酸血症根据病因将其分为两大类:苯丙氨酸羟化酶缺乏和PAH的辅酶四氢生物蝶呤(BH4)缺乏,但两类疾病治疗方法不同。如不能早诊断、早治疗,会对宝宝带来不可逆的伤害。因此,通过二代高通量测序技术,及时、准确地找到致病原因,辅助临床医生对疾病进行确诊,使新生儿得到有效的治疗十分重要。